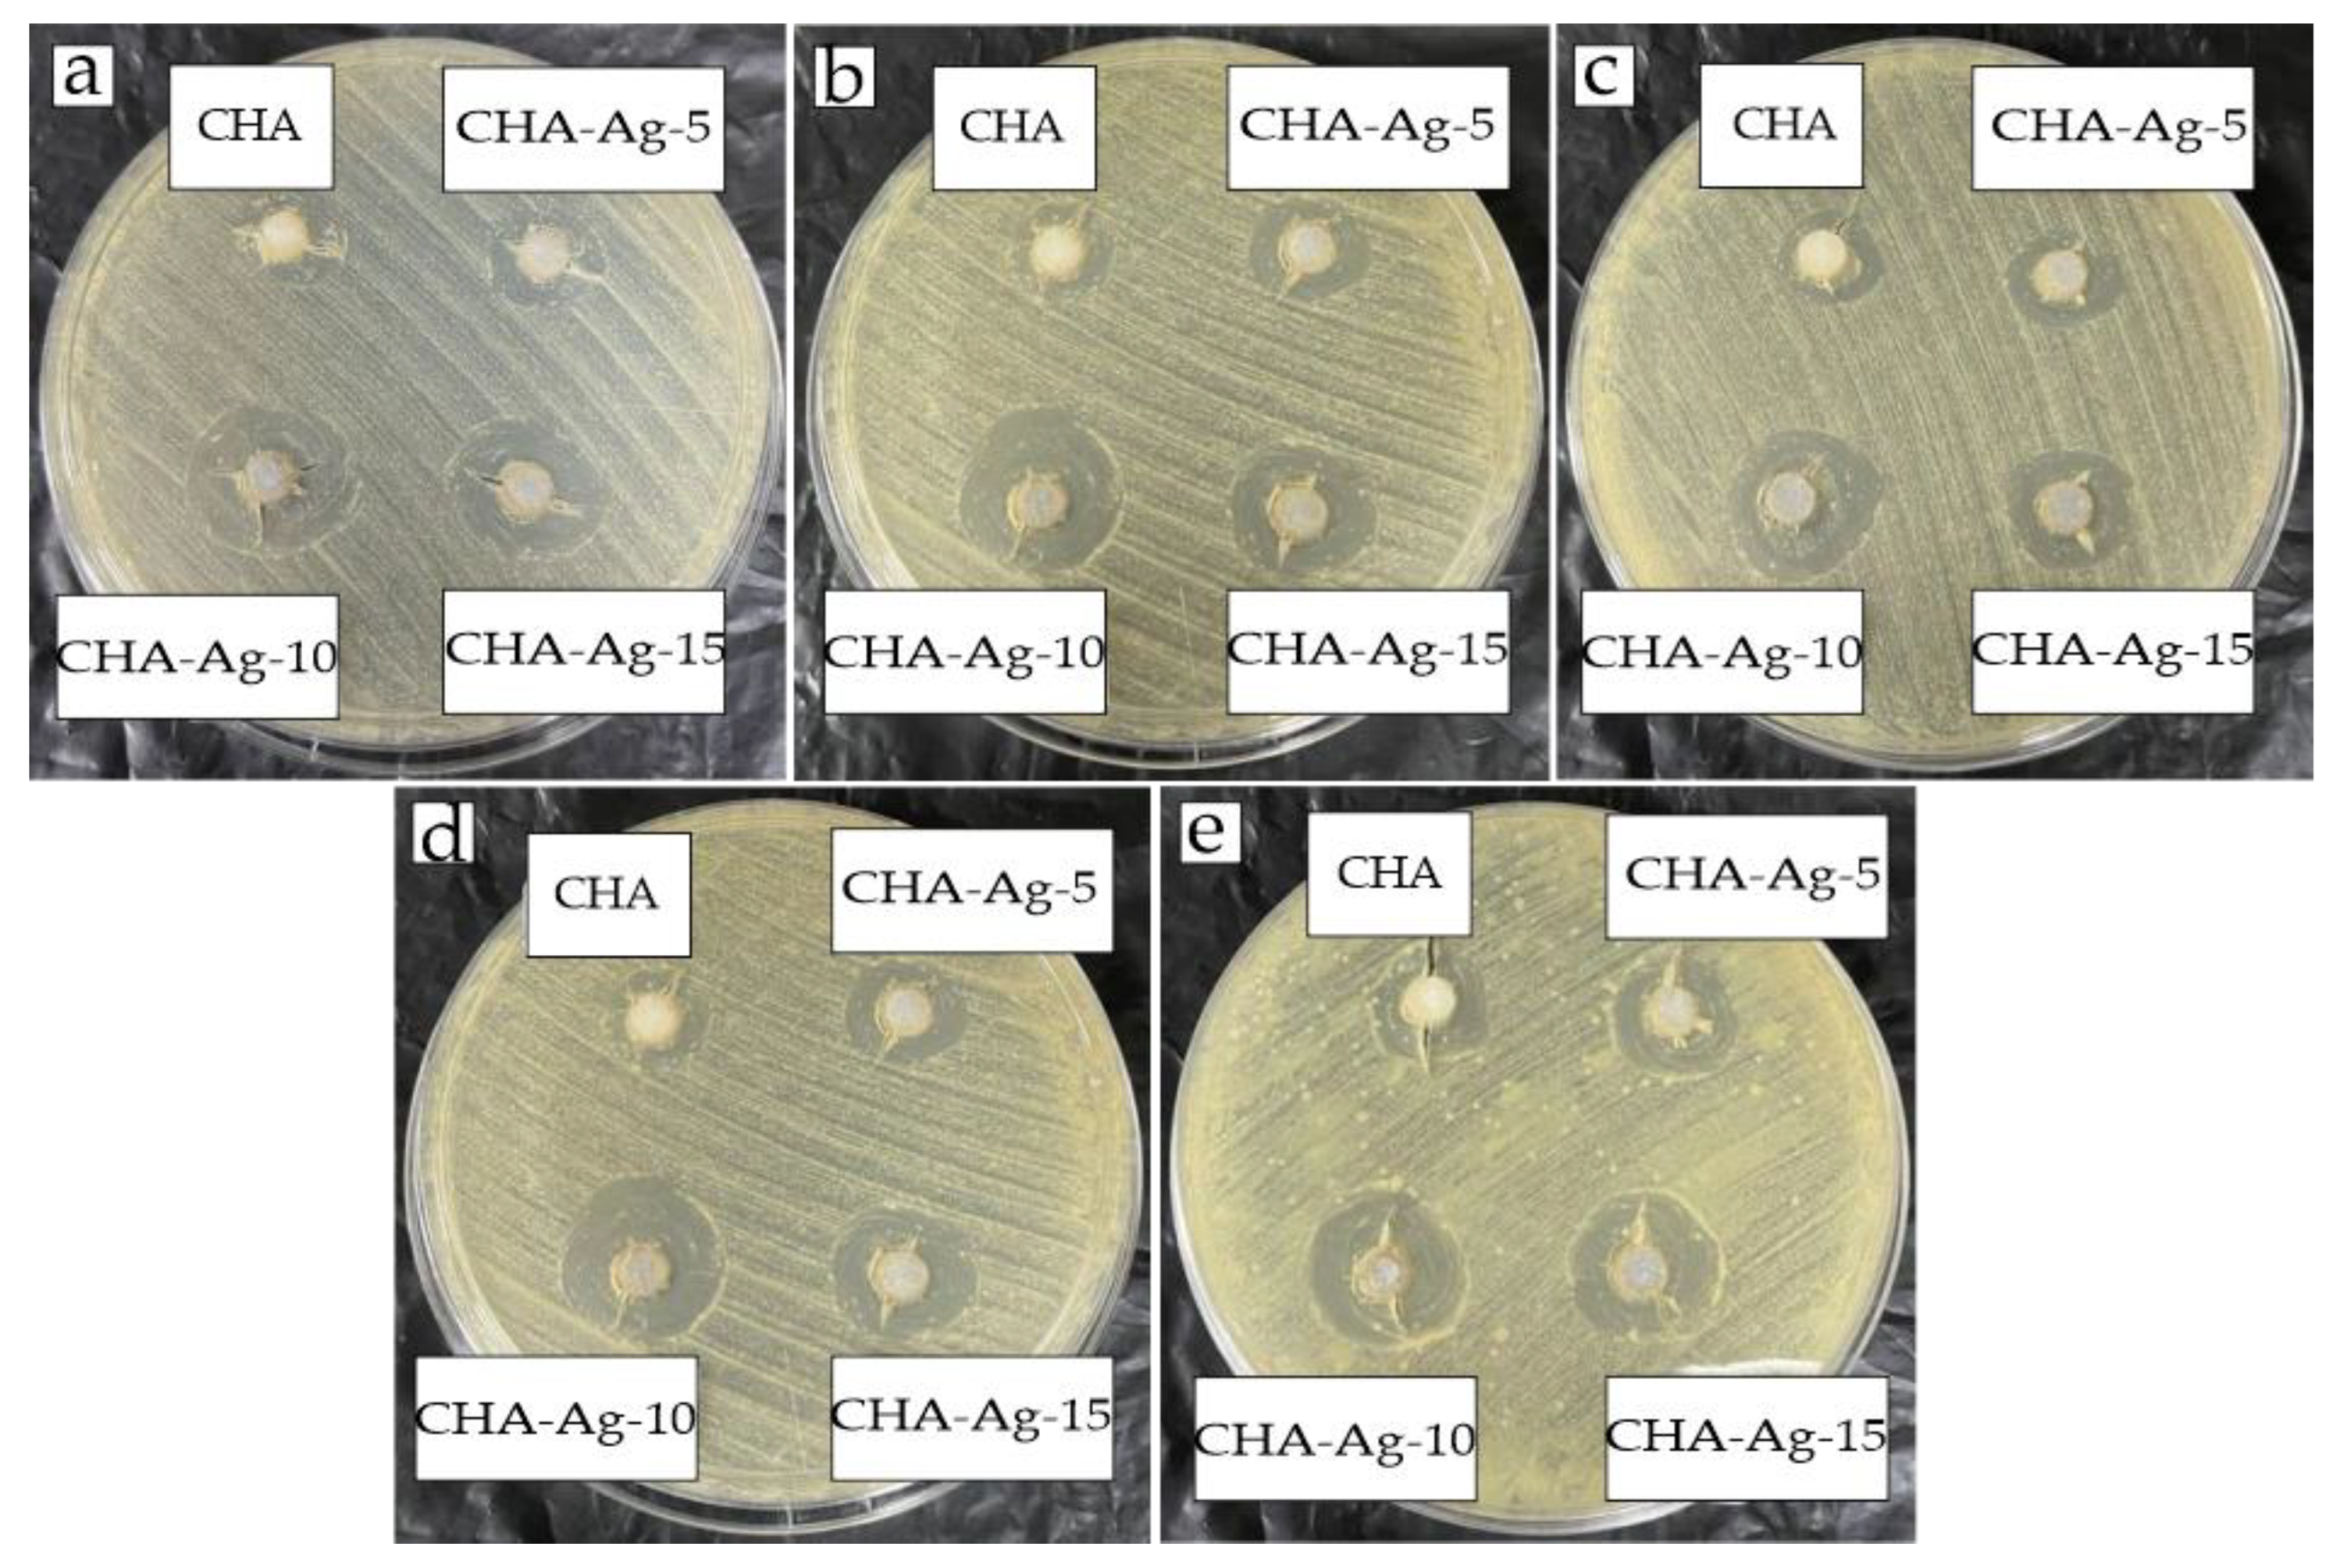
Jfb 14 00385 g005 Jfb 14 00385 g005

Synthesis of Biocompatible Silver-Doped Carbonate Hydroxyapatite Nanoparticles Using Microwave-Assisted Precipitation and In Vitro Studies for the Prevention of Peri-Implantitis
Abstract
1. Introduction
2. Materials and Methods
2.1. Materials
2.2. Methods
2.2.1. Materials Synthesis
2.2.2. Material Characterizations
2.2.3. In Vitro Studies for Antibacterial Properties and Cytotoxicity
2.2.4. Statistical Method
3. Results and Discussion
3.1. Material Characterization
3.2. Antibacterial Activity
3.3. Cytotoxicity Evaluation
4. Conclusions
Author Contributions
Funding
Data Availability Statement
Acknowledgments
Conflicts of Interest
References
- Safi, I.N.; Hussein, B.M.A.; Al Shammari, A.M.; Tawfiq, T.A. Implementation and Characterization of Coating Pure Titanium Dental Implant with Sintered β-TCP by Using Nd:YAG Laser. Saudi Dent. J. 2019, 31, 242–250. [Google Scholar] [CrossRef] [PubMed]
- Prabakaran, S.; Rajan, M.; Geng, Z.; Liu, Y. Fabrication of Substituted Hydroxyapatite-Starch-Clay Bio-Composite Coated Titanium Implant for New Bone Formation. Carbohydr. Polym. 2021, 271, 118432. [Google Scholar] [CrossRef]
- Smeets, R.; Henningsen, A.; Jung, O.; Heiland, M.; Hammächer, C.; Stein, J.M. Definition, Etiology, Prevention and Treatment of Peri-Implantitis-a Review. Head Face Med. 2014, 10, 34. [Google Scholar] [CrossRef] [PubMed]
- Chen, Z.; Wang, Z.; Qiu, W.; Fang, F. Overview of Antibacterial Strategies of Dental Implant Materials for the Prevention of Peri-Implantitis. Bioconjug. Chem. 2021, 32, 627–638. [Google Scholar] [CrossRef] [PubMed]
- Narendran, P.; Rajendran, A.; Garhnayak, M.; Garhnayak, L.; Nivedhitha, J.; Devi, K.C.; Pattanayak, D.K. Influence of PH on Wet-Synthesis of Silver Decorated Hydroxyapatite Nanopowder. Colloids Surf. B Biointerfaces 2018, 169, 143–150. [Google Scholar] [CrossRef] [PubMed]
- Silva-Holguín, P.N.; Reyes-López, S.Y. Synthesis of Hydroxyapatite-Ag Composite as Antimicrobial Agent. Dose-Response 2020, 18, 1–14. [Google Scholar] [CrossRef]
- De Avila, E.D.; van Oirschot, B.A.; van den Beucken, J.J.J.P. Biomaterial-Based Possibilities for Managing Peri-Implantitis. J. Periodontal Res. 2020, 55, 165–173. [Google Scholar] [CrossRef]
- Costa, R.C.; Nagay, B.E.; Bertolini, M.; Costa-Oliveira, B.E.; Sampaio, A.A.; Retamal-Valdes, B.; Shibli, J.A.; Feres, M.; Barão, V.A.R.; Souza, J.G.S. Fitting Pieces into the Puzzle: The Impact of Titanium-Based Dental Implant Surface Modifications on Bacterial Accumulation and Polymicrobial Infections. Adv. Colloid Interface Sci. 2021, 298, 102551. [Google Scholar] [CrossRef] [PubMed]
- Kotsakis, G.A.; Olmedo, D.G. Peri-Implantitis Is Not Periodontitis: Scientific Discoveries Shed Light on Microbiome-Biomaterial Interactions That May Determine Disease Phenotype. Periodontology 2000 2021, 86, 231–240. [Google Scholar] [CrossRef]
- Schwarz, F.; Derks, J.; Monje, A.; Wang, H.L. Peri-Implantitis. J. Periodontol. 2018, 89, S267–S290. [Google Scholar] [CrossRef]
- Nastri, L.; De Rosa, A.; De Gregorio, V.; Grassia, V.; Donnarumma, G. A New Controlled-Release Material Containing Metronidazole and Doxycycline for the Treatment of Periodontal and Peri-Implant Diseases: Formulation and in Vitro Testing. Int. J. Dent. 2019, 2019, 9374607. [Google Scholar] [CrossRef] [PubMed]
- Kormas, I.; Pedercini, C.; Pedercini, A.; Raptopoulos, M.; Alassy, H.; Wol, L.F. Peri-Implant Diseases: Diagnosis, Clinical, Treatment Strategies. A Narrative Review. Antibiotics 2020, 9, 835. [Google Scholar] [CrossRef] [PubMed]
- Lim, P.N.; Chang, L.; Thian, E.S. Development of Nanosized Silver-Substituted Apatite for Biomedical Applications: A Review. Nanomed. Nanotechnol. Biol. Med. 2015, 11, 1331–1344. [Google Scholar] [CrossRef]
- Arciola, C.R.; Campoccia, D.; Montanaro, L. Implant Infections: Adhesion, Biofilm Formation and Immune Evasion. Nat. Rev. Microbiol. 2018, 16, 397–409. [Google Scholar] [CrossRef]
- Agalya, P.; Suresh Kumar, G.; Srinivasan, R.; Prabu, K.M.; Karunakaran, G.; Cholan, S.; Kolesnikov, E.; Kim, M. Hydroxyapatite-Based Antibacterial Bio-Nanomaterials: An Insight into the Synthesis Using Mussel Shell as a Calcium Source, Physicochemical Properties, and Nanoindentation Characteristics. Appl. Phys. 2021, 127, 589. [Google Scholar] [CrossRef]
- Singh, B.; Dubey, A.K.; Kumar, S.; Saha, N.; Basu, B.; Gupta, R. In Vitro Biocompatibility and Antimicrobial Activity of Wet Chemically Prepared Ca10-XAgx(PO4)6(OH)2 (0.0 ≤ x ≤ 0.5) Hydroxyapatites. Mater. Sci. Eng. C 2011, 31, 1320–1329. [Google Scholar] [CrossRef]
- Ciobanu, C.S.; Massuyeau, F.; Constantin, L.V.; Predoi, D. Structural and Physical Properties of Antibacterial Ag-Doped Nano-Hydroxyapatite Synthesized at 100 °C. Nanoscale Res. Lett. 2011, 6, 1–8. [Google Scholar] [CrossRef]
- Costescu, A.; Ciobanu, C.S.; Iconaru, S.L.; Ghita, R.V.; Chifiriuc, C.M.; Marutescu, L.G.; Predoi, D. Fabrication, Characterization, and Antimicrobial Activity, Evaluation of Low Silver Concentrations in Silver-Doped Hydroxyapatite Nanoparticles. J. Nanomater. 2013, 2013, 1–5. [Google Scholar] [CrossRef]
- Porter, A.; Patel, N.; Brooks, R.; Best, S.; Rushton, N.; Bonfield, W. Effect of Carbonate Substitution on the Ultrastructural Characteristics of Hydroxyapatite Implants. J. Mater. Sci. Mater. Med. 2005, 16, 899–907. [Google Scholar] [CrossRef]
- Shaikh, M.S.; Zafar, M.S.; Alnazzawi, A.; Javed, F. Nanocrystalline Hydroxyapatite in Regeneration of Periodontal Intrabony Defects: A Systematic Review and Meta-Analysis. Ann. Anat. 2022, 240, 151877. [Google Scholar] [CrossRef]
- Zuo, G.; Wei, X.; Sun, H.; Liu, S.; Zong, P.; Zeng, X.; Shen, Y. Morphology Controlled Synthesis of Nano-Hydroxyapatite Using Polyethylene Glycol as a Template. J. Alloys Compd. 2017, 692, 693–697. [Google Scholar] [CrossRef]
- Xu, Z.; Qian, G.; Feng, M. Using Polyacrylamide to Control Particle Size and Synthesize Porous Nano Hydroxyapatite. Results Phys. 2020, 16, 102991. [Google Scholar] [CrossRef]
- Kolmas, J.; Piotrowska, U.; Kuras, M.; Kurek, E. Effect of Carbonate Substitution on Physicochemical and Biological Properties of Silver Containing Hydroxyapatites. Mater. Sci. Eng. C 2017, 74, 124–130. [Google Scholar] [CrossRef] [PubMed]
- Safarzadeh, M.; Ramesh, S.; Tan, C.Y.; Chandran, H.; Noor, A.F.M.; Krishnasamy, S.; Alengaram, U.J. Effect of Multi-Ions Doping on the Properties of Carbonated Hydroxyapatite Bioceramic. Ceram. Int. 2019, 45, 3473–3477. [Google Scholar] [CrossRef]
- Sa, Y.; Guo, Y.; Feng, X.; Wang, M.; Li, P.; Gao, Y.; Yang, X.; Jiang, T. Are Different Crystallinity-Index-Calculating Methods of Hydroxyapatite Efficient and Consistent? New J. Chem. 2017, 41, 5723–5731. [Google Scholar] [CrossRef]
- Karunakaran, G.; Cho, E.B.; Kumar, G.S.; Kolesnikov, E.; Janarthanan, G.; Pillai, M.M.; Rajendran, S.; Boobalan, S.; Gorshenkov, M.V.; Kuznetsov, D. Ascorbic Acid-Assisted Microwave Synthesis of Mesoporous Ag-Doped Hydroxyapatite Nanorods from Biowaste Seashells for Implant Applications. ACS Appl. Bio Mater. 2019, 2, 2280–2293. [Google Scholar] [CrossRef]
- Liu, Y.; Tan, Y.; Wu, J. Rubidium Doped Nano-Hydroxyapatite with Cytocompatibility and Antibacterial. J. Asian Ceram. Soc. 2021, 9, 300–310. [Google Scholar] [CrossRef]
- Habraken, W.; Habibovic, P.; Epple, M.; Bohner, M. Calcium Phosphates in Biomedical Applications: Materials for the Future? Mater. Today 2016, 19, 69–87. [Google Scholar] [CrossRef]
- Bohner, M. Design of Ceramic-Based Cements and Putties for Bone Graft Substitution. Eur. Cells Mater. 2010, 20, 3–10. [Google Scholar] [CrossRef]
- Dorozhkin, S.V. Calcium Orthophosphates (CaPO4): Occurrence and Properties. Prog. Biomater. 2016, 5, 9–70. [Google Scholar] [CrossRef]
- Ezekiel, I.; Kasim, S.R.; Ismail YM, B.; Noor, A.F.M. Nanoemulsion Synthesis of Carbonated Hydroxyapatite Nanopowders: Effect of Variant CO32−/PO43− Molar Ratios on Phase, Morphology, and Bioactivity. Ceram. Int. 2018, 44, 13082–13089. [Google Scholar] [CrossRef]
- Kubota, T.; Nakamura, A.; Toyoura, K.; Matsunaga, K. The Effect of Chemical Potential on the Thermodynamic Stability of Carbonate Ions in Hydroxyapatite. Acta Biomater. 2014, 10, 3716–3722. [Google Scholar] [CrossRef]
- Veerla, S.C.; Kim, D.R.; Kim, J.; Sohn, H.; Yang, S.Y. Controlled Nanoparticle Synthesis of Ag/Fe Co-Doped Hydroxyapatite System for Cancer Cell Treatment. Mater. Sci. Eng. C 2019, 98, 311–323. [Google Scholar] [CrossRef] [PubMed]
- Riaz, M.; Zia, R.; Ijaz, A.; Hussain, T.; Mohsin, M.; Malik, A. Synthesis of Monophasic Ag Doped Hydroxyapatite and Evaluation of Antibacterial Activity. Mater. Sci. Eng. C 2018, 90, 308–313. [Google Scholar] [CrossRef] [PubMed]
- Iqbal, N.; Abdul Kadir, M.R.; Nik Malek, N.A.N.; Mahmood, N.H.B.; Murali, M.R.; Kamarul, T. Characterization and Antibacterial Properties of Stable Silver Substituted Hydroxyapatite Nanoparticles Synthesized through Surfactant Assisted Microwave Process. Mater. Res. Bull. 2013, 48, 3172–3177. [Google Scholar] [CrossRef]
- Stanić, V.; Janaćković, D.; Dimitrijević, S.; Tanasković, S.B.; Mitrić, M.; Pavlović, M.S.; Krstić, A.; Jovanović, D.; Raičević, S. Synthesis of Antimicrobial Monophase Silver-Doped Hydroxyapatite Nanopowders for Bone Tissue Engineering. Appl. Surf. Sci. 2011, 257, 4510–4518. [Google Scholar] [CrossRef]
- Kolmas, J.; Oledzka, E.; Sobczak, M.; Nałȩcz-Jawecki, G. Nanocrystalline Hydroxyapatite Doped with Selenium Oxyanions: A New Material for Potential Biomedical Applications. Mater. Sci. Eng. C 2014, 39, 134–142. [Google Scholar] [CrossRef] [PubMed]
- Saikiran, A.; Vivekanand, M.; Prahalad, M.; Yuvan, S.; Rameshbabu, N. Microwave Synthesis of Zn/Mg Substituted and Zn/Mg-F Co-Substituted Nanocrystalline Hydroxyapatite. Mater. Today Proc. 2019, 27, 2355–2359. [Google Scholar] [CrossRef]
- Shitara, K.; Murata, H.; Watanabe, K.; Kojima, C.; Sumida, Y.; Nakamura, A.; Nakahira, A.; Tanaka, I.; Matsunaga, K. Cytotoxicity of Stoichiometric Hydroxyapatites with Different Crystallite Sizes. J. Asian Ceram. Soc. 2014, 2, 64–67. [Google Scholar] [CrossRef]
- Kolmas, J.; Jaklewicz, A.; Zima, A.; Bućko, M.; Paszkiewicz, Z.; Lis, J.; Ślósarczyk, A.; Kolodziejski, W. Incorporation of Carbonate and Magnesium Ions into Synthetic Hydroxyapatite: The Effect on Physicochemical Properties. J. Mol. Struct. 2011, 987, 40–50. [Google Scholar] [CrossRef]
- Kumar, G.S.; Thamizhavel, A.; Yokogawa, Y.; Kalkura, S.N.; Girija, E.K. Synthesis, Characterization and in Vitro Studies of Zinc and Carbonate Co-Substituted Nano-Hydroxyapatite for Biomedical Applications. Mater. Chem. Phys. 2012, 134, 1127–1135. [Google Scholar] [CrossRef]
- Kee, C.C.; Ismail, H.; Mohd Noor, A.F. Effect of Synthesis Technique and Carbonate Content on the Crystallinity and Morphology of Carbonated Hydroxyapatite. J. Mater. Sci. Technol. 2013, 29, 761–764. [Google Scholar] [CrossRef]
- Mirzaee, M.; Vaezi, M.; Palizdar, Y. Synthesis and Characterization of Silver Doped Hydroxyapatite Nanocomposite Coatings and Evaluation of Their Antibacterial and Corrosion Resistance Properties in Simulated Body Fluid. Mater. Sci. Eng. C 2016, 69, 675–684. [Google Scholar] [CrossRef] [PubMed]
- Yusoff, M.F.M.; Kasim, N.H.A.; Himratul-Aznita, W.H.; Saidin, S.; Genasan, K.; Kamarul, T.; Radzi, Z. Physicochemical, Antibacterial and Biocompatibility Assessments of Silver Incorporated Nano-Hydroxyapatite Synthesized Using a Novel Microwave-Assisted Wet Precipitation Technique. Mater. Charact. 2021, 178, 111169. [Google Scholar] [CrossRef]
- Venkateswarlu, K.; Sandhyarani, M.; Nellaippan, T.A.; Rameshbabu, N. Estimation of Crystallite Size, Lattice Strain and Dislocation Density of Nanocrystalline Carbonate Substituted Hydroxyapatite by X-Ray Peak Variance Analysis. Procedia Mater. Sci. 2014, 5, 212–221. [Google Scholar] [CrossRef]
- Deymier, A.C.; Nair, A.K.; Depalle, B.; Qin, Z.; Arcot, K.; Drouet, C.; Yoder, C.H.; Buehler, M.J.; Thomopoulos, S.; Genin, G.M.; et al. Protein-Free Formation of Bone-like Apatite: New Insights into the Key Role of Carbonation. Biomaterials 2017, 127, 75–88. [Google Scholar] [CrossRef]
- Gottardo, B.; Lemes, T.H.; Byzynski, G.; Paziani, M.H.; Von-Zeska-Kress, M.R.; De Almeida, M.T.G.; Volanti, D.P. One-Pot Synthesis and Antifungal Activity of Nontoxic Silver-Loaded Hydroxyapatite Nanocomposites against Candida Species. ACS Appl. Nano Mater. 2019, 2, 2112–2120. [Google Scholar] [CrossRef]
- Pajor, K.; Pajchel, Ł.; Zgadzaj, A.; Piotrowska, U.; Kolmas, J. Modifications of Hydroxyapatite by Gallium and Silver Ions—Physicochemical Characterization, Cytotoxicity and Antibacterial Evaluation. Int. J. Mol. Sci. 2020, 21, 5006. [Google Scholar] [CrossRef]
- Shen, J.; Jin, B.; Qi, Y.; Jiang, Q.; Gao, X. Carboxylated Chitosan/Silver-Hydroxyapatite Hybrid Microspheres with Improved Antibacterial Activity and Cytocompatibility. Mater. Sci. Eng. C 2017, 78, 589–597. [Google Scholar] [CrossRef]
- Kędziora, A.; Speruda, M.; Krzyżewska, E.; Rybka, J.; Łukowiak, A.; Bugla-Płoskońska, G. Similarities and Differences between Silver Ions and Silver in Nanoforms as Antibacterial Agents. Int. J. Mol. Sci. 2018, 19, 444. [Google Scholar] [CrossRef]
- Patty, D.J.; Nugraheni, A.D.; Ana, I.D.; Yusuf, Y. Dual Functional Carbonate-Hydroxyapatite Nanocomposite from Pinctada Maxima and Egg-White for Bone Tissue Engineering. J. Biomater. Sci. Polym. Ed. 2022, 33, 1043–1062. [Google Scholar] [CrossRef]
- Kleanthous, C.; Armitage, J.P. The Bacterial Cell Envelope. Philos. Trans. R. Soc. B Biol. Sci. 2015, 370, 20150019. [Google Scholar] [CrossRef]
- Cheeseman, S.; Christofferson, A.J.; Kariuki, R.; Cozzolino, D.; Daeneke, T.; Crawford, R.J.; Truong, V.K.; Chapman, J.; Elbourne, A. Antimicrobial Metal Nanomaterials from Passive to Stimuli-Activated Applications. Adv. Sci. 2020, 7, 1902913. [Google Scholar] [CrossRef]
- Godoy-Gallardo, M.; Eckhard, U.; Delgado, L.M.; de Roo Puente, Y.J.D.; Hoyos-Nogués, M.; Gil, F.J.; Perez, R.A. Antibacterial Approaches in Tissue Engineering Using Metal Ions and Nanoparticles: From Mechanisms to Applications. Bioact. Mater. 2021, 6, 4470–4490. [Google Scholar] [CrossRef]
- Ferraz, M.P.; Monteiro, F.J.; Manuel, C.M. Hydroxyapatite Nanoparticles: A Review of Preparation Methodologies. J. Appl. Biomater. Biomech. 2004, 2, 74–80. [Google Scholar]
- Kuo, Z.K.; Lai, P.L.; Toh, E.K.W.; Weng, C.H.; Tseng, H.W.; Chang, P.Z.; Chen, C.C.; Cheng, C.M. Osteogenic Differentiation of Preosteoblasts on a Hemostatic Gelatin Sponge. Sci. Rep. 2016, 6, 32884. [Google Scholar] [CrossRef]
- Pascua-Maestro, R.; Corraliza-Gomez, M.; Diez-Hermano, S.; Perez-Segurado, C.; Ganfornina, M.D.; Sanchez, D. The MTT-Formazan Assay: Complementary Technical Approaches and in Vivo Validation in Drosophila Larvae. Acta Histochem. 2018, 120, 179–186. [Google Scholar] [CrossRef] [PubMed]
- Prakash, K.H.; Kumar, R.; Ooi, C.P.; Cheang, P.; Khor, K.A. Apparent Solubility of Hydroxyapatite in Aqueous Medium and Its Influence on the Morphology of Nanocrystallites with Precipitation Temperature. Langmuir 2006, 22, 11002–11008. [Google Scholar] [CrossRef]
- Webster, T.J.; Massa-Schlueter, E.A.; Smith, J.L.; Slamovich, E.B. Osteoblast Response to Hydroxyapatite Doped with Divalent and Trivalent Cations. Biomaterials 2004, 25, 2111–2121. [Google Scholar] [CrossRef] [PubMed]
- Shi, Z.; Huang, X.; Cai, Y.; Tang, R.; Yang, D. Size Effect of Hydroxyapatite Nanoparticles on Proliferation and Apoptosis of Osteoblast-like Cells. Acta Biomater. 2009, 5, 338–345. [Google Scholar] [CrossRef]

| Materials | Stoichiometry | ||||
|---|---|---|---|---|---|
| Ca(NO3)2 | AgNO3 | (NH4)2HPO4 | Na2CO3 | ||
| HA | - | 10 | - | 6 | - |
| CHA | - | 10 | - | 6 | 6 |
| CHA-Ag-05 | 0.005 | 9.95 | 0.05 | 6 | 6 |
| CHA-Ag-10 | 0.010 | 9.90 | 0.10 | 6 | 6 |
| CHA-Ag-14 | 0.015 | 9.85 | 0.15 | 6 | 6 |
| Materials | Element (%Mass) | Ca/P | |||
|---|---|---|---|---|---|
| Ca | P | O | Na | ||
| HA | 27.40 | 15.20 | 48.74 | - | 1.39 |
| CHA | 28.51 | 14.91 | 45.32 | 1.25 | 1.48 |
| CHA-Ag-05 | 25.59 | 13.65 | 48.53 | 1.38 | 1.45 |
| CHA-Ag-10 | 27.99 | 15.08 | 45.62 | 1.33 | 1.43 |
| CHA-Ag-15 | 34.41 | 16.68 | 40.56 | 0.92 | 1.59 |
| Materials | Lattice Constant | Crystallinity (%) | Crystallite Size (nm) | Particle Size (nm) 1 | |
|---|---|---|---|---|---|
| a | c | ||||
| HA | 9.358 | 6.837 | 63.3 | 28.29 | 23.47 |
| CHA | 9.339 | 6.854 | 43.6 | 25.00 | 21.42 |
| CHA-Ag-05 | 9.344 | 6.866 | 15.0 | 17.49 | 16.98 |
| CHA-Ag-10 | 9.350 | 6.867 | 15.9 | 17.86 | 16.55 |
| CHA-Ag-15 | 9.349 | 6.864 | 16.4 | 18.02 | 16.72 |
| In the Group of | Significance | ||
|---|---|---|---|
| Normality Test | Homogeneity Test | ANOVA | |
| Bacteria | >0.05 | >0.05 | 0.00 |
| Materials | >0.05 | >0.05 | 0.00 |
Disclaimer/Publisher’s Note: The statements, opinions and data contained in all publications are solely those of the individual author(s) and contributor(s) and not of MDPI and/or the editor(s). MDPI and/or the editor(s) disclaim responsibility for any injury to people or property resulting from any ideas, methods, instructions or products referred to in the content. |
© 2023 by the authors. Licensee MDPI, Basel, Switzerland. This article is an open access article distributed under the terms and conditions of the Creative Commons Attribution (CC BY) license (https://creativecommons.org/licenses/by/4.0/).
Share and Cite
Aziz, S.; Ana, I.D.; Yusuf, Y.; Pranowo, H.D. Synthesis of Biocompatible Silver-Doped Carbonate Hydroxyapatite Nanoparticles Using Microwave-Assisted Precipitation and In Vitro Studies for the Prevention of Peri-Implantitis. J. Funct. Biomater. 2023, 14, 385. https://doi.org/10.3390/jfb14070385
Aziz S, Ana ID, Yusuf Y, Pranowo HD. Synthesis of Biocompatible Silver-Doped Carbonate Hydroxyapatite Nanoparticles Using Microwave-Assisted Precipitation and In Vitro Studies for the Prevention of Peri-Implantitis. Journal of Functional Biomaterials. 2023; 14(7):385. https://doi.org/10.3390/jfb14070385
Chicago/Turabian StyleAziz, Saifuddin, Ika Dewi Ana, Yusril Yusuf, and Harno Dwi Pranowo. 2023. "Synthesis of Biocompatible Silver-Doped Carbonate Hydroxyapatite Nanoparticles Using Microwave-Assisted Precipitation and In Vitro Studies for the Prevention of Peri-Implantitis" Journal of Functional Biomaterials 14, no. 7: 385. https://doi.org/10.3390/jfb14070385
APA StyleAziz, S., Ana, I. D., Yusuf, Y., & Pranowo, H. D. (2023). Synthesis of Biocompatible Silver-Doped Carbonate Hydroxyapatite Nanoparticles Using Microwave-Assisted Precipitation and In Vitro Studies for the Prevention of Peri-Implantitis. Journal of Functional Biomaterials, 14(7), 385. https://doi.org/10.3390/jfb14070385

